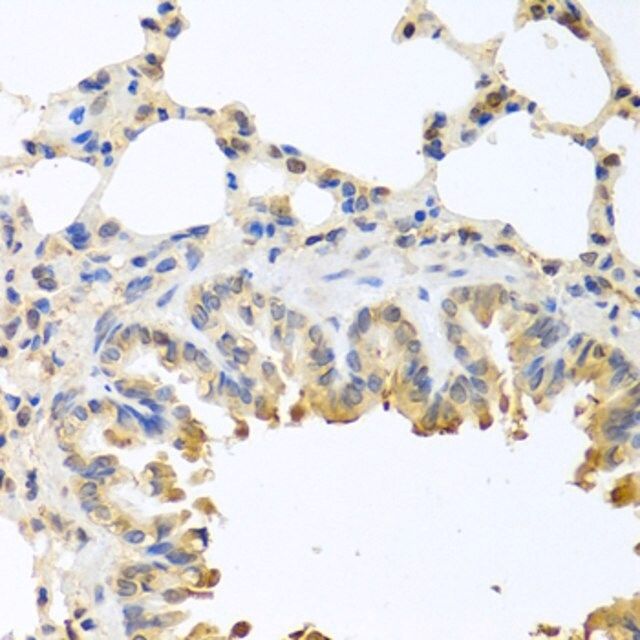

产品说明
一般描述
The protein encoded by this gene belongs to the BCL2 protein family. BCL2 family members form hetero- or homodimers and act as anti- or pro-apoptotic regulators that are involved in a wide variety of cellular activities. This protein forms a heterodimer with BCL2, and functions as an apoptotic activator. This protein is reported to interact with, and increase the opening of, the mitochondrial voltage-dependent anion channel (VDAC), which leads to the loss in membrane potential and the release of cytochrome c. The expression of this gene is regulated by the tumor suppressor P53 and has been shown to be involved in P53-mediated apoptosis. Multiple alternatively spliced transcript variants, which encode different isoforms, have been reported for this gene.
免疫原
A synthetic peptide corresponding to a sequence within amino acids 1-100 of human BAX (NP_620116.1).
外形
PBS with 0.02% sodium azide,50% glycerol,pH7.3.
储存及稳定性
Store at -20℃. Avoid freeze / thaw cycles.
产品性质
| 生物来源 | rabbit |
| 质量水平 | 100 |
| 抗体形式 | affinity isolated antibody |
| antibody product type | primary antibodies |
| 克隆 | polyclonal |
| 形式 | buffered aqueous solution |
| 分子量 | 12 15 18 19 21 24 4 kDa |
| species reactivity | human, mouse, rat |
| 浓度 | 1.09 mg/ml |
| technique(s) | immunofluorescence: 1:50-1:200 immunohistochemistry: 1:50-1:100 western blot: 1:500-1:2000 |
| UniProt登记号 | Q07812 |
| 运输 | wet ice |
| 储存温度 | −20℃ |
| Gene Information | human ... BAX(581) |
安全信息
| 储存分类代码 | 12 - Non Combustible Liquids |
| WGK | WGK 1 |
| 闪点(F) | Not applicable |
| 闪点(C) | Not applicable |